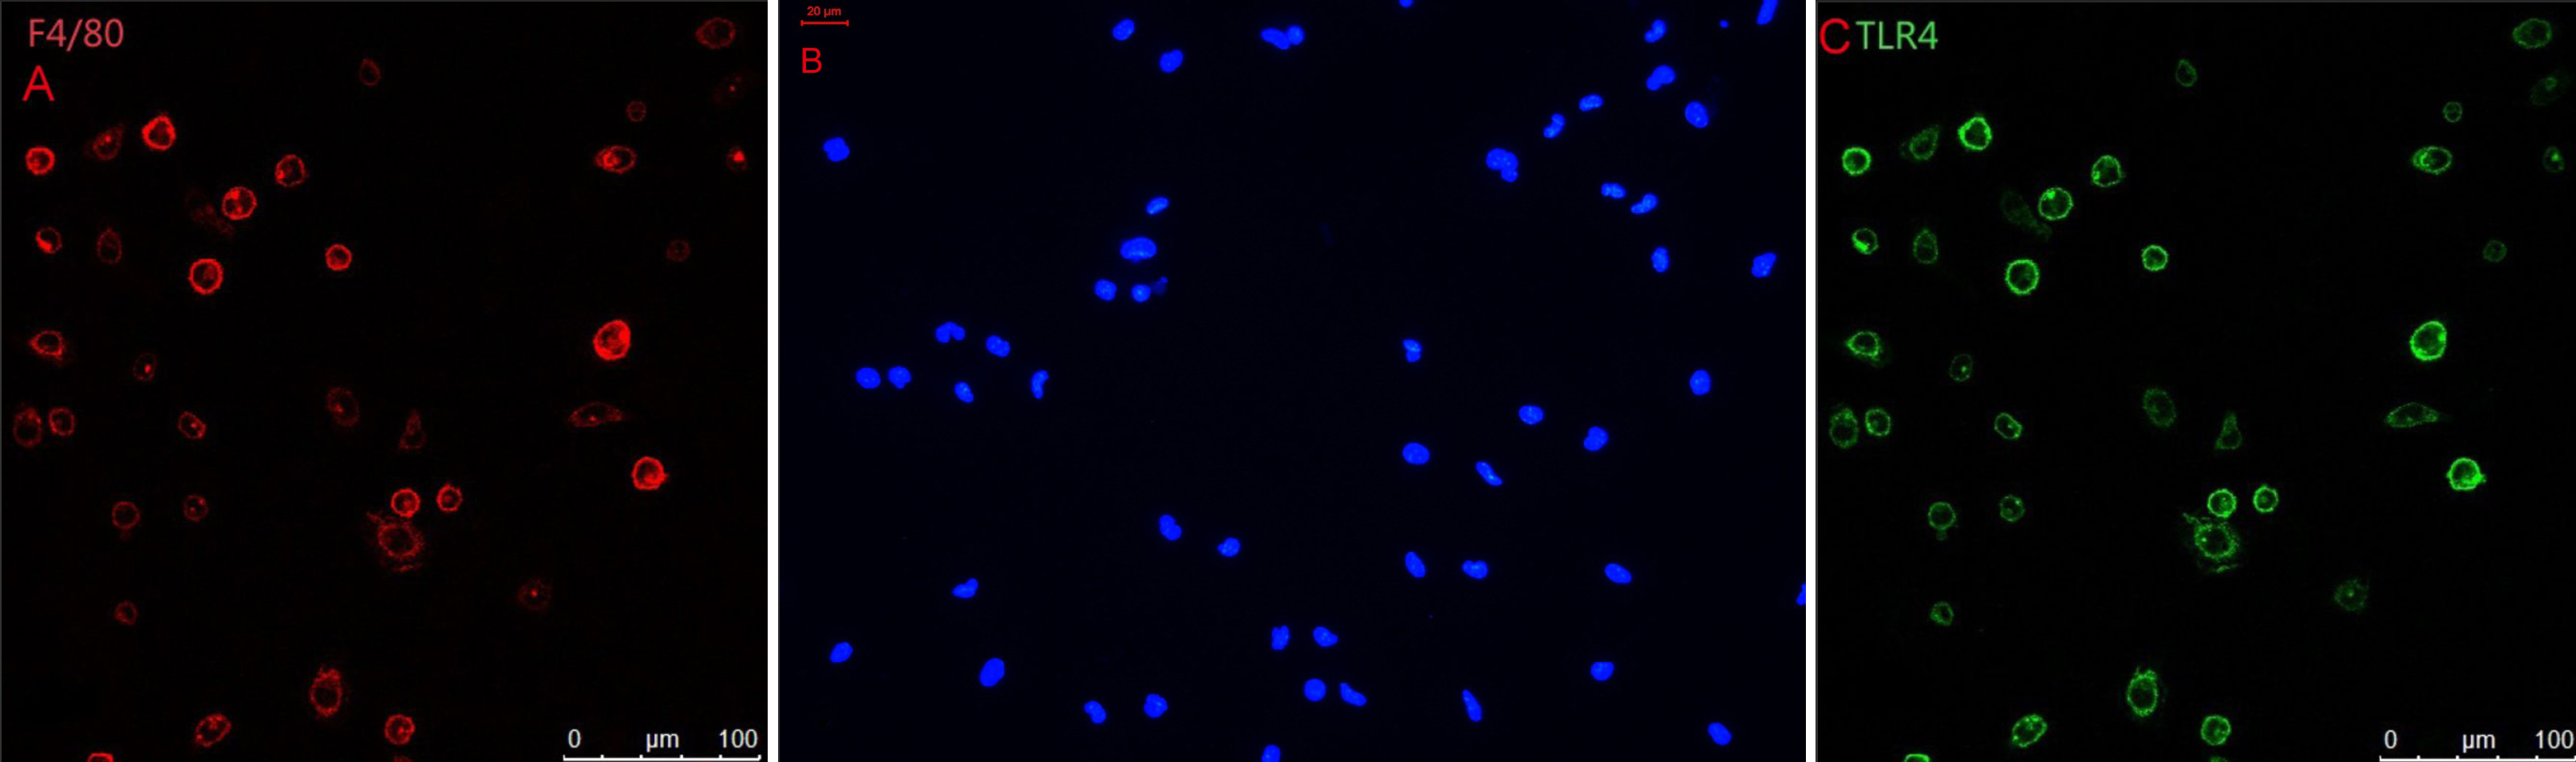

Figure 3. Immunohistochemical studies for
TLR4 and F4/80. A: Unstimulated C3H/HeN mouse peritoneal
macrophages were marked with F4/80 staining. Cells were approximately
round. B: No staining was seen when under identical
experimental conditions when the primary antibody was replaced with
normal IgG at the same concentration (negative control). C: The
TLR4+ cells of C3H/HeN mice possessed round-ovoid morphology, expressed
in the membrane without LPS stimulation.